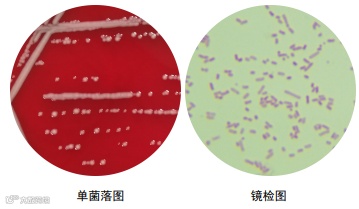

喵星人、汪星人给“铲屎官”们带来不少快乐,抚摸成了主人向萌宠表达爱意的方式。但人们在享受撸猫逗狗带来欢乐的同时,也要小心被宠物抓伤咬伤的情况,因为除了感染狂犬病,也可能藏着其他可怕的细菌。广州医科大学附属第五医院 ( 以下简称 " 广医五院 ")就收治了两位不幸 " 中招 " 的患者,伤口溃烂不止甚至还伴有黄黑色腐肉出现!

其中一位患者王阿姨先是在 4 天前被家里的小猫咬伤了右小腿,当下虽伤口处疼痛还伴有明显的局部红肿,但王阿姨没当一回事,仅简单处理了下伤口。本以为伤口会慢慢痊愈,结果情况却正好相反。几天后,王阿姨的伤情越来越严重,不仅伤口难以愈合且不断扩大,肿胀也一直消不下来,且时常有血性脓液渗出,害怕的王阿姨赶紧来到医院就诊。
在一组检查中,医护人员找到了问题所在。
王阿姨的伤口分泌物被送往该院医学检验科微生物组培养,发现血平板上有中等大小、不溶血、呈灰白色、光滑、湿润的菌落生长和革兰染色为革兰阴性短杆菌,通过飞行时间质谱仪鉴定结果为 " 多杀巴斯德菌 "。
" 多杀巴斯德菌一般以家禽和野生动物作为宿主,常常寄生在宿主的肠道和呼吸道当中,当患者被动物(如猫、狗)咬伤后容易发生感染。"医生特别指出,由于夏天天气炎热,满身毛的宠物也容易烦躁不安,一向温顺的猫猫狗狗也有可能做出过激行为,加之人们穿着清凉,被咬伤抓伤的可能性变得更高。
一旦咬伤抓伤后被确诊感染多杀巴斯德菌,患者伤口会出现红肿、压痛、流脓等症状,部分患者在伤口红肿部分还会呈现青紫、花斑状的改变。感染后,严重的患者会引起肺部感染甚至导致菌血症,多表现为发热、咳嗽、咳痰等。
其中,尤其针对抵抗力比较弱的婴幼儿和老人来说,还极有可能引发伤口感染,如诱发细菌性脑膜炎。特别是有婴幼儿或老人的家庭,要尽量避免接触猫、狗,以免发生多杀巴斯特菌感染。同时建议 " 铲屎官 " 们日常要做好宠物的清洁和卫生饲养工作,定期为爱宠打疫苗和洗澡清洁,并定期清理排泄物。
天佑晶创®锌系抗菌剂拥有一系列成熟的抗菌技术,可用于油漆、涂料、板材,热塑性塑料,热固性塑料,硅胶等材料。可以根据所需的功效以及材料特性和使用条件,制造出符合要求的抗菌化学品。目前已经与多个家电品牌如九阳、小天鹅等企业建立良好的合作关系,为他们提供各个方面的抗菌方案。




